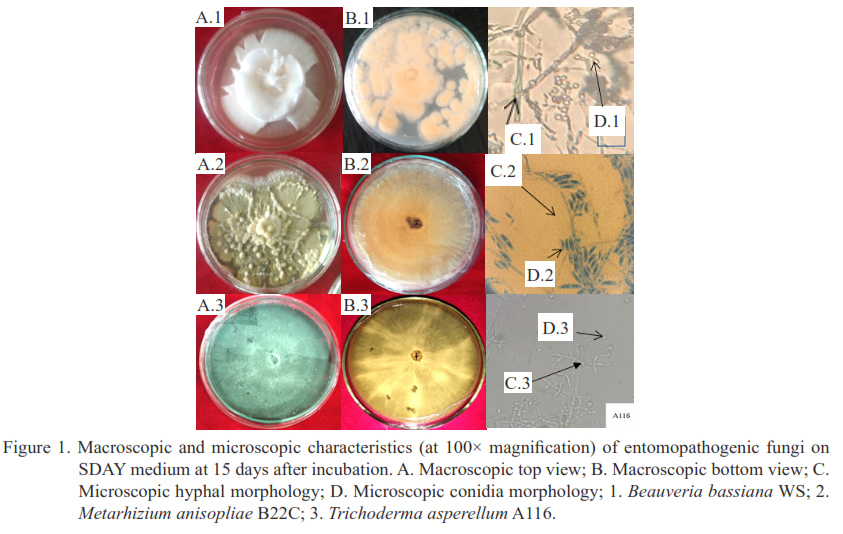

Effectiveness of entomopathogenic fungal combinations on eggs and larval development of Spodoptera frugiperda J.E. Smith (Lepidoptera: Noctuidae) in corn plants
Main Article Content
Abstract
Spodoptera frugiperda J.E. Smith is an invasive pest of corn, requiring effective and environmentally friendly control strategies. This study aimed to evaluate the effectiveness of three entomopathogenic fungal (EPF) isolates, namely Beauveria bassiana WS, Metarhizium anisopliae B22C, and Trichoderma asperellum A116, tested as single isolates or in combination against S. frugiperda eggs and larvae. The experiment used a Completely Randomized Design (CRD) with eight treatments (three single treatments, four combinations, and a control) and four replications. Conidial suspensions were applied by spraying onto eggs and second-instar larvae. Parameters observed included the percentage of unhatched eggs, larval mortality, and pupal and adult development. Chitinase, protease, and lipase activities were qualitatively tested to support the identification of pathogenicity mechanisms. Data were analyzed using analysis of variance (ANOVA), followed by the LSD test at a 5% significance level. The results showed that EPF combinations increased mortality and inhibited the development of S. frugiperda. The combination of B. bassiana WS + T. asperellum A116 was the most effective treatment, inhibiting egg hatching by 85% and reducing pupal and adult formation to 25.95% and 12.96%, respectively. The highest mortality of first-instar larvae was observed in the single treatment of B. bassiana WS and the tertiary combination of B. bassiana WS + M. anisopliae B22C + T. asperellum A116, at 24.18% and 22.91%, respectively. Consistent enzymatic activity indicated potential biocontrol synergy through the production of cuticle-degrading enzymes. This combination is recommended for field-scale testing as an environmentally friendly alternative to reduce dependence on chemical insecticides.
Article Details

This work is licensed under a Creative Commons Attribution-NonCommercial 4.0 International License.
References
Adriyani R. 2006. Usaha pengendalian pencemaran lingkungan akibat penggunaan pestisida pertanian [Control of environmental pollution caused by pesticide in agricultural process]. Jurnal Kesehatan Lingkungan. 3(1): 95–106.
Alfasiri A. 2025. Pengendalian Spodoptera frugipera J.E. Smith (Lepidoptera: Noctuidae] menggunakan beberapa strain cencawan endofit Trichoderma asperellum Samuels, Lieckf & Nirenberg pada tanaman jagung [Control of Spodoptera frugiperda J.E. Smith (Lepidoptera: Noctuidae) by using several strain of endophytic fungus Trichoderma asperellum Samuels, Lieckf & Nirenberg in maize. Master Thesis. Universitas Andalas. Padang.
Akutse KS, Kimemia JW, Ekesi S, Khamis FM, Ombura OL, & Subramanian S. 2019. Ovicidal effects of entomopathogenic fungal isolates on the invasive fall armyworm Spodoptera frugiperda (Lepidoptera: Noctuidae). J. Appl. Entomol. 143(6): 626–634. https://doi.org/10.1111/jen.12634
Bamisile BS, Adesina JM, & Ofuya TI. 2014. Relative Susceptibility and proximate composition of some imported and local rice varieties to infestation and damage by Sitophilus oryzae L. (Coleoptera: Curculionidae). Mol. Entomol. 5(3): 18–29.
Batool R, Umer MJ, Wang Y, He K. Zhang T, Bai S, Zhi Y, Chen J, & Wang Z. 2020. Synergistic effect of Beauveria bassiana and Trichoderma asperellum to induce maize (Zea mays L.) defense against the asian corn borer, Ostrinia furnacalis (Lepidoptera, Crambidae). Int. J. Mol. Sci. 21(21): 8215. https://doi.org/10.3390/ijms21218215
BPS-Statistics Indonesia. 2021. Analisis Produktivitas Jagung dan Kedelai di Indonesia 2020 (Hasil Survei Ubinan) [Analysis of Corn and Soybean Productivity in Indonesia 2020]. https://www.bps.go.id/id/publication/2021/07/27/16e8f4b2ad77dd7de2e53ef2/analisis-produktivitas-jagung-dan-kedelai-di-indonesia-2020--hasil-survei-ubinan-.html. Accessed on 24 June 2025.
Directorate of Food Crop Protection. 2020. Pedoman Operasional: Pengamatan dan Pengendalian Spodoptera frugiperda pada Jagung [Operational Guidelines for Observation & Control of Spodoptera frugiperda in Corn]. Direktorat Perlindangan Tanaman Pangan. Direktorat Jenderal Tanaman Pangan. kementrian Pertanian. Jakarta. https://repository.pertanian.go.id/handle/123456789/24863. Accessed on 2 May 2025.
Clarkson JM & Charnley AK. 1996. New insights into the mechanisms of fungal pathogenesis in insects. Trends Microbiol. 4(5): 197–203. https://doi.org/10.1016/0966-842x
Correa-Cuadros JP, Sáenz-Aponte A, & Rodríguez-Bocanegra MX. 2016. In vitro interaction of Metarhizium anisopliae Ma9236 and Beauveria bassiana Bb9205 with Heterorhabditis bacteriophora HNI0100 for the control of Plutella xylostella. SpringerPlus. 5(1): 2068. https://doi.org/10.1186/s40064-016-3745-5
Deb L & Dutta P. 2021. Antagonistic potential of Beauveria bassiana (Balsamo) Vuillemin against Pythium myriotylum causing damping of of tomato. Indian Phytopathol. 74(3): 715–728. https://doi.org/10.1007/s42360-021-00372-w
da Silva PF, dos Santos MSN, Araújo BdA, Kerber BD, de Oliveira HAP, Guedes JVC, Mazutti MA, Tres MV, & Zabot GL. 2025. Co-cultivations of Beauveria bassiana, Metarhizium anisopliae, and Trichoderma harzianum to produce bioactive compounds for application in agriculture. Fermentation. 11(1): 30. https://doi.org/10.3390/fermentation11010030
Dhawan M & Joshi N. 2017. Enzymatic comparison and mortality of Beauveria bassiana against cabbage caterpillar Pieris brassicae LINN. Braz. J. Microbiol. 48(3): 522–529. https://doi.org/10.1016/j.bjm.2016.08.004
Effendy TA, Septiadi R, Salim A, & Mazid A. 2010. Jamur entomopatogen asal tanah lebak di Sumatera Selatan dan potensinya sebagai agensia hayati walang sangit (Leptocorisa oratorius (F.) [Entomopathogenic fungi from the lowland soil of South Sumatera and their potential as biocontrol agents of stink bug (Leptocorisa oratorius (F.)]. J. Trop. Plant Pests Dis. 10(2): 154–161. https://doi.org/10.23960/j.hptt.210154-161
Faddilah DR, Verawaty M, & Herlinda S. 2022. Growth of fall armyworm, Spodoptera frugiperda J.E. Smith (Lepidoptera: Noctuidae) fed on young maize colonized with endophytic fungus Beauveria bassiana from South Sumatra, Indonesia. Biodiversitas. 23(12): 6652–6660. https://doi.org/10.13057/biodiv/d231264
Flawerina G, Trizelia, & Nurbailis. 2021. Virulence of five isolates of indigenous Beauveria bassiana against eggs and nymphs of Bemisia tabaci Gennadius (Hemiptera: Aleyrodidae). Curr. Agric. Res. J. 9(1): 54–61. https://doi.org/10.12944/CARJ.9.1.07
Ginting S, Chozin M, & Sudjatmiko S. 2024. Infestation of Spodoptera frugiperda on corn in Bengkulu at different elevations. J. Trop. Plant Pests Dis. 24(1): 38–47. https://doi.org/10.23960/jhptt.12438-47
Giridhar D, Ravi SN, Kirian KV, Kartheek D, Rajanikanth P, & Nagalakshmi DM. 2012. Purification, characterization and antifungal activity of chitinase from Trichoderma viride N9. J. Cell Tissue Research. 12(2): 3187–3192.
Golzan SR, Talaei-Hassanloui R, Homayoonzadeh M, & Safavi SA. 2023. Role of cuticle-degrading enzymes of Beauveria bassiana and Metarhizium anisopliae in virulence on Plodia interpunctella (Lepidoptera, Pyralidae) larvae. J. Asia-Pac. Entomol. 26(2): 102038. https://doi.org/10.1016/j.aspen.2023.102038
Gómez-Valderrama J, Cuartas-Otálora P, Espinel-Correal C, Barrera-Cubillos G, & Villamizar-Rivero L. 2022. Fungal and viral entomopathogens as a combined strategy for the biological control of fall armyworm larvae in maize. CABI Agric. Biosci. 3(1): 24. https://doi.org/10.1186/s43170-022-00094-7
Harith-Fadzilah N, Ghani IA, & Hassan M. 2020. Omics-based approach in characterising mechanisms of entomopathogenic fungi pathogenicity: A case example of Beauveria bassiana. J. King Saud Univ. Sci. 33(2): 101332. https://doi.org/10.1016/j.jksus.2020.101332
Harrison RD, Thierfelder C, Baudron F, Chinwada P, Midega C, Schaffner U, & Van den Berg J. 2019. Agro-ecological options for fall armyworm (Spodoptera frugiperda JE Smith) management: Providing low-cost, smallholder friendly solutions to an invasive pest. J. Environ. Manag. 243: 318–330. https://doi.org/10.1016/j.jenvman.2019.05.011
Herlinda S, Utama MD, Pujiastuti Y, & Suwandi. 2006. Kerapatan dan viabilitas spora Beauveria bassiana (Bals.) akibat subkultur dan pengayaan media, serta virulensinya terhadap larva Plutella xylostella. (Linn.) [Density and viability of spores of Beauveria bassiana (Bals.) Vuill. due to sub-cultures and media enriched, and its virulence against larvae of Plutella xylostella (Linn.)]. J. Trop. Plant Pests Dis. 6(2): 70–78. https://doi.org/10.23960/j.hptt.2670-78
Idrees A, Afzal A, Qadir ZA, & Li J. 2023. Virulence of entomopathogenic fungi against fall armyworm, Spodoptera frugiperda (Lepidoptera: Noctuidae) under laboratory conditions. Front. Physiol. 14: 1107434. https://doi.org/10.3389/fphys.2023.1107434
Idrees A, Qadir ZA, Akutse KS, Afzal A, Hussain M, Islam W, Waqas MS, Bamisile BS, & Li J. 2021. Effectiveness of entomopathogenic fungi on immature stages and feeding performance of fall armyworm, Spodoptera frugiperda (Lepidoptera: Noctuidae) larvae. Insects. 12(11): 1044. https://doi.org/10.3390/insects12111044
Islam MdS, Subbiah VK, & Siddiquee S. 2022. Efficacy of entomopathogenic Trichoderma isolates against sugarcane woolly aphid, Ceratovacuna lanigera Zehntner (Hemiptera: Aphididae). Horticulturae. 8(1): 2. https://doi.org/10.3390/horticulturae8010002
Kumela T, Simiyu J, Sisay B, Likhayo P, Mendesil E, Gohole L, & Tefera T. 2018. Farmers knowledge, perceptions, and management practices of the new invasive pest, fall armyworm (Spodoptera frugiperda) in Ethiopia and Kenya. Int. J. Pest Manag. 65(1): 1–9. https://doi.org/10.1080/09670874.2017.1423129
Lestari YA, Verawaty M, & Herlinda S. 2022. Development of Spodoptera frugiperda fed on young maize plant’s fresh leaves inoculated with endophytic fungi from South Sumatra, Indonesia. Biodiversitas. 23(10): 5056–5063. https://doi.org/10.13057/biodiv/d231012
Lestari P, Swibawa IG, Fitriana Y, Suharjo R, Utomo SD, & Hartaman M. 2024. The population dynamics of Spodoptera frugiperda after its invasion in Lampung Province, Indonesia. J. Trop. Plant Pests Dis. 24(1): 98–108. https://doi.org/10.23960/jhptt.12498-108
Meilin A, Rubiana R, Jumakir, Suheiti K, Murni WS, Rustam, & Bobihoe J. 2020. Study of pest attacks on maize plantation in the oil palm replanting land of Jambi Province. IOP Conf. Ser.: Earth Environ. Sci. 752: 012008. https://doi.org/10.1088/1755-1315/752/1/012008
Nazir T, Basit A, Hanan A, Majeed MZ, & Qiu D. 2018. In vitro pathogenicity of some entomopathogenic fungal strains against green peach aphid Myzus persicae (Homoptera: Aphididae). Agronomy. 9(1): 7. https://doi.org/10.3390/agronomy9010007
Nonci N, Kalqutny SH, Mirsam H, Muis A, Azrai M, & Aqil M. 2019. Pengenalan Fall Armyworm (Spodoptera frugiperda J.E. Smith) Hama Bary pada Tanaman Jagung di Indonesia [Introduction of fall armyworm (Spodoptera frugiperda J.E. Smith), a new pest on corn crops in Indonesia [in Indonesian]. Balai Penelitian Tanaman Serealia Maros. https://share.google/V1v3JcVQ3Z01qMLQx. Accessed on 30 June 2025.
Oberti H, Sessa L, van Roosmalen E, de Bekker C, Seidl MF, Sanches-Vallet A, & Abreo E. 2025. From omics to enhanced fungal virulence: Overexpression of a putative secreted protein improves Beauveria bassiana biocontrol potential against the insect pests Piezodorus guildinii. Pest Manag Sci, 82: 3205-3215. https://doi.org/10.1002/ps.70442
Pauli G, Mascarin GM, Eilenberg J, & Júnior ID. 2018. Within-host competition between two entomopathogenic fungi and a granulovirus in Diatraea saccharalis (Lepidoptera: Crambidae). Insects. 9(2): 64. https://doi.org/10.3390/insects9020064
Peng Y, Li SJ, Yan J, Tang Y, Cheng JP, Gao AJ, Yao X, Ruan JJ, & Xu BL. 2021. Research progress on phytopathogenic fungi and their role as biocontrol agents. Front. Microbiol. 12: 670135. https://doi.org/10.3389/fmicb.2021.670135
Prayogo Y. 2010. Lecanicillium lecanii sebagai bioinsektisida untuk pengendalian telur hama kepik coklat pada kedelai [Lecanicillium lecanii as a bioinsecticide for controlling brown planthopper eggs on soybeans]. Iptek Tanaman Pangan. 5(2): 169–182.
Prayogo. 2013. Patogenisitas cendawan entomopatogen Beauveria bassiana (Deuteromycotina: Hyphomycetes) pada berbagai stadia kepik hijau (Nezara viridula L.) [Pathogenicity of Beauveria bassiana Bals. Vuill. (Deuteromycotina:Hyphomycetes) on various stages of eggs and nymphs of the green stink bug (Nezara viridula L.)]. J. Trop. Plant Pests Dis. 13(1): 75–86. https://doi.org/10.23960/j.hptt.11375-86
Půža V & Tarasco E. 2023. Interactions between entomopathogenic fungi and entomopathogenic nematodes. Microorganisms. 11(1): 163. https://doi.org/10.3390/microorganisms11010163
Quesada Moraga E, Garrido Jurado I, Yousef-Yousef M, & González-Mas N. 2022. Multitrophic interactions of entomopathogenic fungi in BioControl. BioControl. 67(5): 457–472. https://doi.org/10.1007/s10526-022-10163-5
Ramatsitsi N, Dube ZP, Ramachela K, & Motloba T. 2025. Bio-control efficacy of selected indigenous nematophagous fungi against Meloidogyne enterolobii in vitro and on dry bean (Phaseolus vulgaris L.). Int. Microbiol. 28(1): 151–160. https://doi.org/10.1007/s10123-024-00571-1
Rizkie L, Herlinda S, Suwandi, Irsan C, Susilawati, Lakitan B. 2017. Kerapatan dan viabilitas konidia Beauveria bassiana dan Metarhizium anisopliae pada media in vitro pH rendah [Conidial density and viability of Beauveria bassiana and Metarhizium anisopliae grown on the low-pH in vitro medium]. J. Trop. Plant Pests Dis. 17(2): 119–127. https://doi.org/10.23960/j.hptt.217119-127
Saciloto-de-Oliveira LR, Broetto L, Alves CI, da Rosa RL, Alves YPC, da Silva RC, Berger M, Macedo AJ, Dalberto PF, Bizarro CV, Guimarães JA, Yates JR, Santi L, & Beys-da-Silva WO. 2023. Metarhizium anisopliae E6 secretome reveals molecular players in host specificity and toxicity linked to cattle tick infection. Fungal Biol. 127(7–8): 1136–1145. https://doi.org/10.1016/j.funbio.2023.06.006
Sandy G, Ratih S, Suharjo R, & Akin HM. 2019. Pengaruh Trichoderma sp. sebagai agen peningkatan ketahanan tanaman padi terhadap penyakit hawar daun [The effect of Trichoderma sp. as an agent for increasing rice plant resistance to leaf blight disease]. J. Agrotek Tropika. 7(3): 423–432. https://doi.org/10.23960/jat.v7i3.3546
Saputra RD, Hadiastono T, Afandhi A, & Bedjo B. 2016. Sinergisme Spodoptera litura Nuclear Polyhedrosis Virus JTM 97C (SlNPV-JTM 97C) dengan ekstrak biji sirsak (Annona muricata L.) dalam pengendalian Helicoverpa armigera Hubner (Lepidoptera: Noctuidae) pada tanaman kedelai (Glycine max L.) di laboratorium [Synergism of Spodoptera litura Nuclear Polyhedrosis Virus JTM 97C (SlNPV-JTM 97C) with soursop seed extract (Annona muricata L.) in controlling Helicoverpa armigera Hubner (Lepidoptera: Noctuidae) on soybean plants (Glycine max L.) in the laboratory]. Jurnal HPT (Hama Penyakit Tumbuhan). 3(3): 26–33. https://jurnalhpt.ub.ac.id/index.php/jhpt/article/view/197
Sari JMP, Herlinda S, & Suwandi. 2022. Endophytic fungi from South Sumatra (Indonesia) in seed-treated corn seedlings affecting development of the fall armyworm, Spodoptera frugiperda J.E. Smith (Lepidoptera: Noctuidae). Egypt J. Biol. Pest Control. 32(1): 1–11. https://doi.org/10.1186/s41938-022-00605-8
Sari JMP, Herlinda S, Suwandi, & Elfita. 2023. Effect of Beauveria bassiana and Metarhizium anisopliae on the growth of Spodoptera frugiperda by seed inoculation. Biodiversitas. 24(4): 2350–2357. https://doi.org/10.13057/biodiv/d240449
Sarma BK, Yadav SK, Singh S, & Singh HB. 2015. Microbial consortium-mediated plant defense against phytopathogens: Readdressing for enhancing e cacy. Soil Biol. Biochem. 87: 25–33. https://doi.org/10.1016/j.soilbio.2015.04.001
Sharma R & Sharma P. 2021. Fungal entomopathogens: A systematic review. Egypt J. Biol. Pest Control. 31(1): 57. https://doi.org/10.1186/s41938-021-00404-7
Stuart AKdC, Furuie JL, Zawadneak MAC, & Pimentel IC. 2020. Increased mortality of the european pepper moth Duponchelia fovealis (Lepidoptera: Crambidae) using entomopathogenic fungal consortia. J. Invertebr. Pathol. 177: 107503. https://doi.org/10.1016/j.jip.2020.107503
Trisyono YA, Suputa, Aryuwandari VEF, Hartaman M, & Jumari. 2019. Occurrence of heavy infestation by the fall armyworm Spodoptera frugiperda, a new alien invasive pest, in corn in Lampung Indonesia. J. Plant Prot. 23(1): 156–160. https://doi.org/10.22146/jpti.46455
Trizelia. 2005. Cendawan Entomopatogen Beauveria bassiana (Bals.) Vuill. (Deuteromycotina: Hyphomycetes): Keragaman Genetik, Karakterisasi Fisiologi dan Virulensinya terhadap Crocidolomia pavonana (F.) (Lepidoptera: Pyralidae [The entomopathogenic fungus Beauveria bassiana (Bals.) Vuill. (Deuteromycotina: Hyphomycetes): Genetic diversity, physiological characterization, and virulence against Crocidolomia pavonana (F.) (Lepidoptera: Pyralidae). Dissertation. Institut Pertanian Bogor. Bogor.
Trizelia, Yanti Y, & Suhriani. 2019. Potensi jamur entomopatogen Beauveria bassiana (Bals.) untuk mengendalikan kutu kubis Eurydema pulchrum Westw. (Hemiptera: Pentatomidae) [Potential of entomopathogenic fungus Beauveria bassiana (bals.) for controlling cabbage bug Eurydema pulchrum Westw. (Hemiptera: Pentatomidae). Prosiding National Seminar. pp. 346–352. Sunan Gunung Jati State Islamic University. Bandung.
Vajri IY, Trizelia, Kuswardani RA, & Saragih M. 2024. Cendawan entomopatogen sebagai penginduksi ketahanan tanaman: Sebuah tinjauan sistematis [Entomopathogenic fungi as plant resistance inducer: A systematic review]. Jurnal Entomologi Indonesia. 21(1): 76–91. https://doi.org/10.5994/jei.21.1.75
Wang H, Peng H, Li W, Cheng P, & Gong M. 2021. The toxins of Beauveria bassiana and the strategies to improve their virulence to insects. Front. Microbiol. 12: 705343. https://doi.org/10.3389/fmicb.2021.705343
Wang X, Ding X, Yuan Z, Jia Z, Fu K, Zhan F, Guo W, Zhou L, Li H, Dai J, Wang Z, Xie Y, & Yang X. 2023. Analysis of the virulence, infection process, and extracellular enzyme activities of Aspergillus nomius against the asian corn borer, Ostrinia furnacalis guenée (Lepidoptera: Crambidae). Virulence. 14(1): 2265108. https://doi.org/10.1080/21505594.2023.2265108
Zhang D, Xiao Y, Xu P, Yang X, Wu Q, & Wu K. 2021. Insecticide resistance monitoring for the invasive populations of fall armyworm, Spodoptera frugiperda in China. J. Integr. Agric. 20(3): 783–791. https://doi.org/10.1016/S2095-3119(20)63392-5